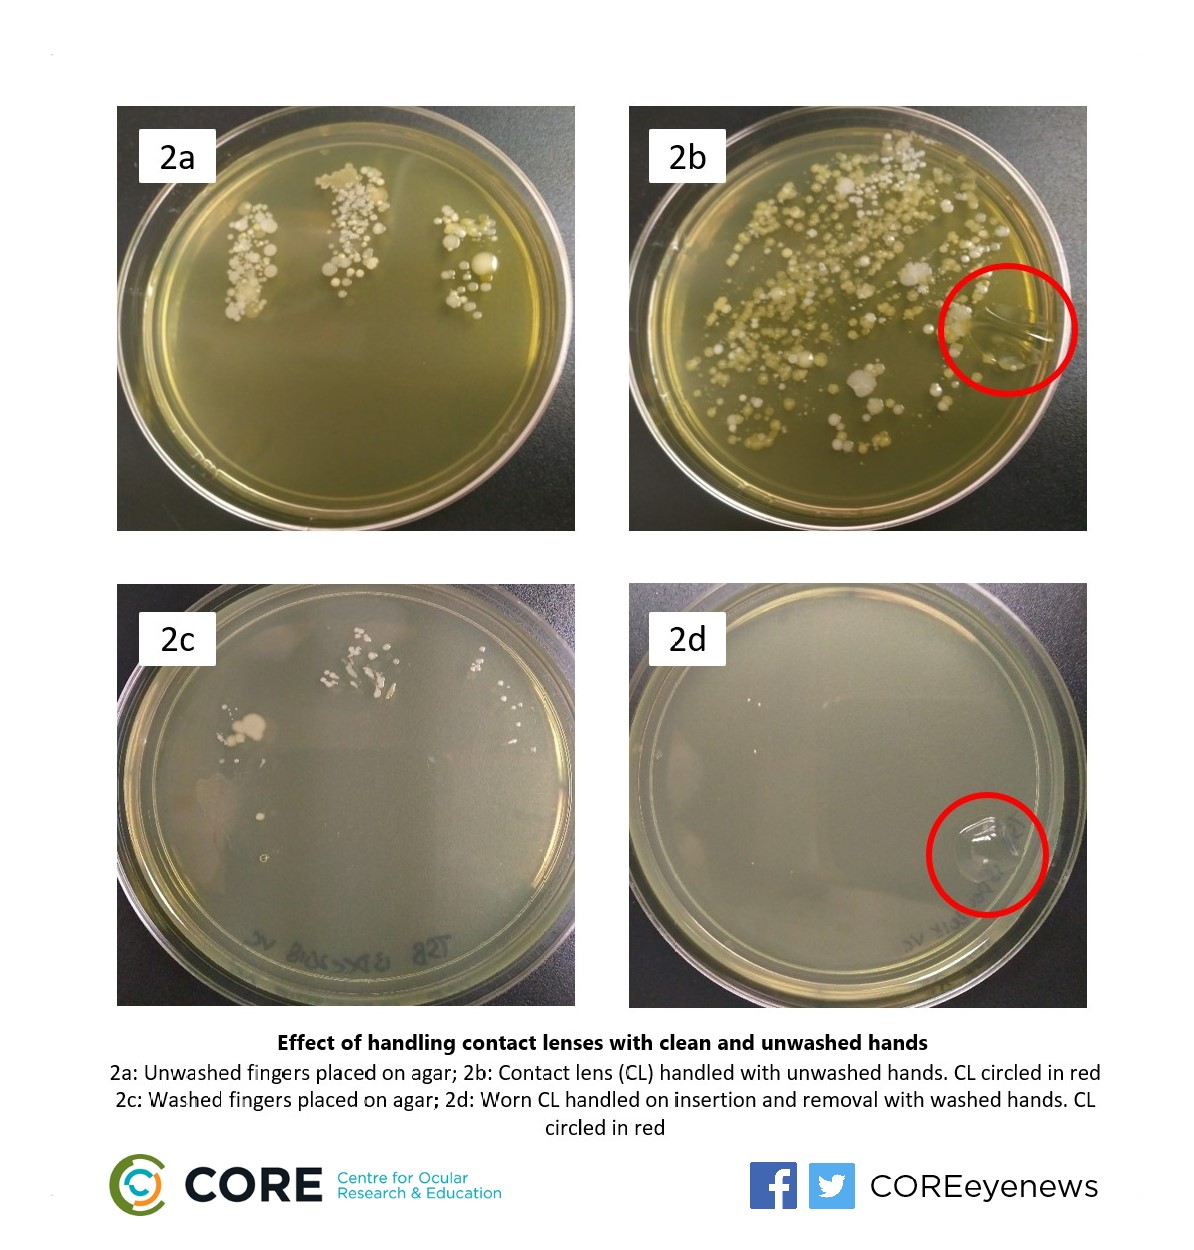

Researchers welcome heightened hand-washing focus
Contact lens researchers in Canada have welcomed the global focus on hand-washing techniques, citing research showing proper hand hygiene is especially important for contact lens wearers.
A recent literature review from Professor Emeritus Desmond Fonn and the Centre for Ocular Research & Education (CORE) reported that proper hand hygiene was especially important for people who used contact lenses. The peer-reviewed study, published in Contact Lens and Anterior Eye, drew attention to how hand-washing habits could affect the development of contact lens related microbial keratitis, which can be severe and sight-threatening, and corneal inflammatory events.
“Everyone is suddenly Googling hand-washing techniques with the spread of Covid-19,” said Lyndon Jones, the paper’s co-author and director of CORE. “Clearly this is sensible advice to help reduce the risk of transferring the virus, however, outside of the current crisis, focus on good hand-washing techniques should be mandatory for contact lens wearers too. With the amount of information available on this topic right now, it is timely to remind lens wearers of just how much the simple act of thorough hand washing can reduce their risk of lens-related complications occurring.”
The paper noted that in line with its ability to reduce the spread of disease, careful and thorough hand-washing with soap and water – followed by hand drying with unused paper towels – should greatly reduce the transfer of microbial contamination from hands to the contact lens or eye. Clean hands plus the use of daily disposables resulted in the lowest risk of contact lens-related complications. For wearers of reusable lenses, there are additional guidelines on lens and case cleaning which can be downloaded for patient use from CORE’s Contact Lens Update educational resource.
In 2018, CORE published a series of photos that demonstrated the rapid growth of bacteria associated with mishandling contact lenses (see right). CORE researchers exposed new, clean contact lenses to both clean and unwashed hands. Unwashed hands were pressed into agar (Figure 2a), and also used to handle a new contact lens (Figure 2b). Scientists then repeated the procedure after following recommended hand-washing practices, touching both the agar directly, along with applying and removing a contact lens (Figures 2c and 2d).
In 2018, CORE published a series of photos that demonstrated the rapid growth of bacteria associated with mishandling contact lenses (see right). CORE researchers exposed new, clean contact lenses to both clean and unwashed hands. Unwashed hands were pressed into agar (Figure 2a), and also used to handle a new contact lens (Figure 2b). Scientists then repeated the procedure after following recommended hand-washing practices, touching both the agar directly, along with applying and removing a contact lens (Figures 2c and 2d).
The results demonstrated the impact handling had on contact lenses: samples that had been touched with unwashed hands showed significantly higher numbers of visible bacteria. By comparison, the contact lens touched with clean hands had only a minimal bacterial load.
“Contact lenses are a safe, highly effective form of vision correction used by millions of people worldwide, but ignoring good contact lens care can have a devastating effect on eye health and vision,” said CORE senior research associate, Miriam Heynen, who conducted the experiment with laboratory research assistant Vivian Chan. “Taking care of your contact lenses with clean, dry hands is essential, a point that is clearly illustrated in the images shared here.”
Photos from the handling study are available for use by eyecare professionals and contact lens wearers here.
Dr Jones concluded by saying: “We understand the relevance of good hand-washing practices for everyone in the current climate of Covid-19. Beyond the current heightened focus, it is also prudent to remind contact lens wearers of their ongoing need to conduct good hand hygiene prior to touching their lenses and eyes.”